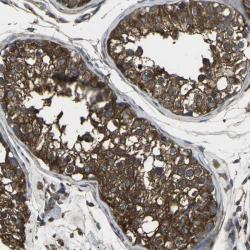

Antibody data
- Antibody Data
- Antigen structure
- References [4]
- Comments [0]
- Validations
- Western blot [1]
- Immunohistochemistry [1]
Submit
Validation data
Reference
Comment
Report error
- Product number
- sc-904 - Provider product page

- Provider
- Santa Cruz Biotechnology
- Proper citation
- Santa Cruz Biotechnology Cat#sc-904, RRID:AB_2170182
- Product name
- Anti-PRKACB
- Antibody type
- Polyclonal (Antigen purified)
- Antigen
- Synthetic peptide
- Reactivity
- Human
- Host
- Rabbit
Submitted references CREB up-regulates long non-coding RNA, HULC expression through interaction with microRNA-372 in liver cancer.
Suppression of LPS-induced TNF-alpha production in macrophages by cAMP is mediated by PKA-AKAP95-p105.
TGF-beta receptor levels regulate the specificity of signaling pathway activation and biological effects of TGF-beta.
A versatile approach to multiple gene RNA interference using microRNA-based short hairpin RNAs.
Wang J, Liu X, Wu H, Ni P, Gu Z, Qiao Y, Chen N, Sun F, Fan Q
Nucleic acids research 2010 Sep;38(16):5366-83
Nucleic acids research 2010 Sep;38(16):5366-83
Suppression of LPS-induced TNF-alpha production in macrophages by cAMP is mediated by PKA-AKAP95-p105.
Wall EA, Zavzavadjian JR, Chang MS, Randhawa B, Zhu X, Hsueh RC, Liu J, Driver A, Bao XR, Sternweis PC, Simon MI, Fraser ID
Science signaling 2009 Jun 16;2(75):ra28
Science signaling 2009 Jun 16;2(75):ra28
TGF-beta receptor levels regulate the specificity of signaling pathway activation and biological effects of TGF-beta.
Rojas A, Padidam M, Cress D, Grady WM
Biochimica et biophysica acta 2009 Jul;1793(7):1165-73
Biochimica et biophysica acta 2009 Jul;1793(7):1165-73
A versatile approach to multiple gene RNA interference using microRNA-based short hairpin RNAs.
Zhu X, Santat LA, Chang MS, Liu J, Zavzavadjian JR, Wall EA, Kivork C, Simon MI, Fraser ID
BMC molecular biology 2007 Oct 30;8:98
BMC molecular biology 2007 Oct 30;8:98
No comments: Submit comment
Supportive validation
- Submitted by
- per
- Main image

- Experimental details
- Western blot analysis of antibody specificity using a routine panel composed of IgG/HSA-depleted human plasma and protein lysates from selected human tissues and cell lines.
- Validation comment
- Band of predicted size in kDa (+/-20%) with additional bands present.
- Primary Ab dilution
- 1:500
- Secondary Ab dilution
- 1:3000
- Lane 1
- Marker [kDa]: 213, 118, 83, 50, 33, 26, 18
- Lane 2
- RT-4
- Lane 3
- U-251MG sp
- Lane 4
- Human Plasma
- Lane 5
- Liver
- Lane 6
- Tonsil
- Theoretical target weight
- [kDa] 40
Supportive validation
- Submitted by
- per
- Main image
- Experimental details
- Immunohistochemical staining of human testis shows strong cytoplasmic positivity in cells of seminiferus ducts.
- Validation comment
- Staining pattern partly consistent with experimental and/or bioinformatic data.
 Explore
Explore Validate
Validate Learn
Learn Western blot
Western blot